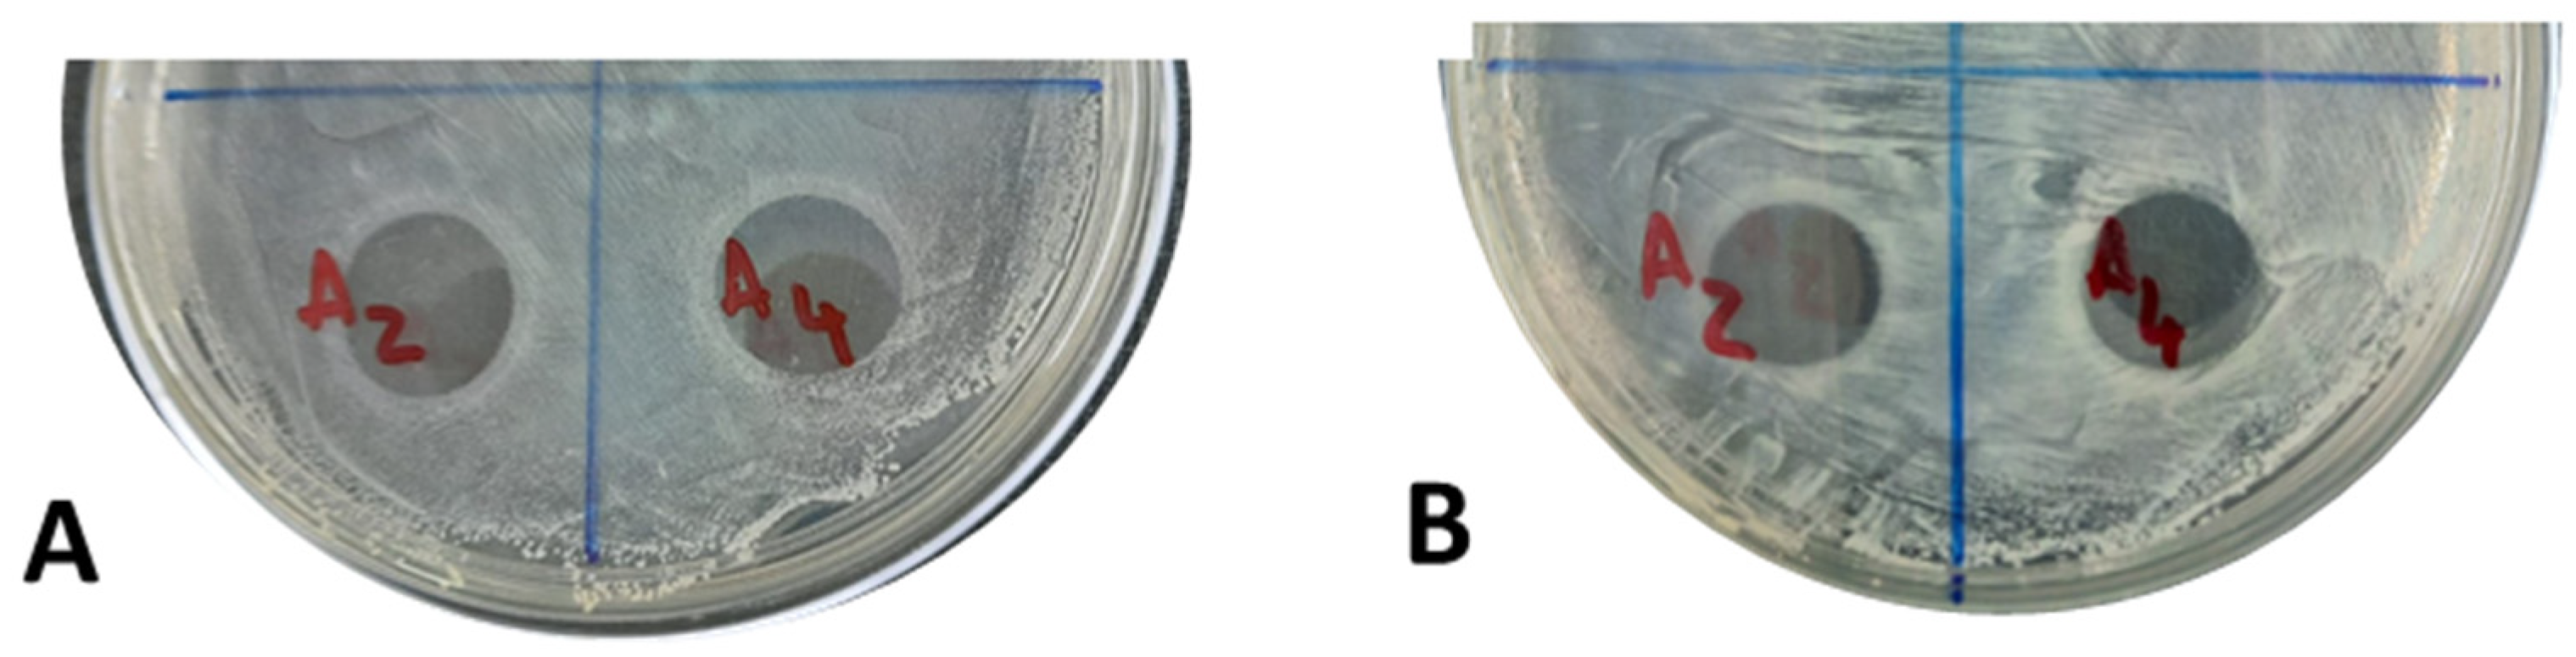
Ddc 02 00026 g007

Antimicrobial Nanoformulations Based on Schinus areira Essential Oil
Abstract
:1. Introduction
2. Results and Discussion
2.1. Obtaining and Characterizing S. areira EO
2.2. S. areira EO Formulations
2.2.1. Encapsulation of EO into Liposomes
2.2.2. Green Synthesis and Characterization of AgNPs
2.2.3. Size and Zeta Potential of Formulations
2.3. Antimicrobial Activity of the Formulations
3. Materials and Methods
3.1. Materials
3.2. Obtaining Essential Oil and Chemical Characterization
3.3. Encapsulation of EO into Liposomes
3.4. Encapsulation Efficiency (EE)
3.5. Green Synthesis of AgNPs and Characterization
3.6. Size and Zeta Potential Measurements of EO Formulations
3.7. MIC and MBC Determination
3.8. Evaluation of Antibacterial Activity by the Plate Diffusion Technique
3.9. Reproducibility and Statistical Treatment of Data
4. Conclusions
Supplementary Materials
Author Contributions
Funding
Institutional Review Board Statement
Informed Consent Statement
Data Availability Statement
Acknowledgments
Conflicts of Interest
References
- Solis-Quispe, L.; Tomaylla-Cruz, C.; Callo-Choquelvica, Y.; Solís-Quispe, A.; Rodeiro, I.; Hernández, I.; Fernández, M.D.; Pino, J.A. Chemical composition, antioxidant and antiproliferative activities of essential oil from Schinus areira L. and Minthostachys spicata (Benth.) Epl. grown in Cuzco, Peru. J. Essent. Oil Res. 2016, 28, 234–240. [Google Scholar] [CrossRef]
- Dhifi, W.; Bellili, S.; Jazi, S.; Bahloul, N.; Mnif, W. Essential Oils’ Chemical Characterization and Investigation of Some Biological Activities: A Critical Review. Medicines 2016, 3, 25. [Google Scholar] [CrossRef] [Green Version]
- Hyldgaard, M.; Mygind, T.; Meyer, R.L. Essential oils in food preservation: Mode of action, synergies, and interactions with food matrix components. Front. Microbiol. 2012, 3, 12. [Google Scholar] [CrossRef] [Green Version]
- Rosato, A.; Piarulli, M.; Corbo, F.; Muraglia, M.; Carone, A.; Vitali, M.; Vitali, C. In Vitro Synergistic Action of Certain Combinations of Gentamicin and Essential Oils. Curr. Med. Chem. 2010, 17, 3289–3295. [Google Scholar] [CrossRef]
- Swamy, M.K.; Akhtar, M.S.; Sinniah, U.R. Antimicrobial properties of plant essential oils against human pathogens and their mode of action: An updated review. Evid.-Based Complement. Altern. Med. 2016, 2016, 3012462. [Google Scholar] [CrossRef] [Green Version]
- Ekrami, A.; Ghadermazi, M.; Ekrami, M.; Hosseini, M.A.; Emam-Djomeh, Z.; Hamidi-Moghadam, R. Development and evaluation of Zhumeria majdae essential oil-loaded nanoliposome against multidrug-resistant clinical pathogens causing nosocomial infection. J. Drug Deliv. Sci. Technol. 2022, 69, 103148. [Google Scholar] [CrossRef]
- Donsì, F.; Ferrari, G. Essential oil nanoemulsions as antimicrobial agents in food. J. Biotechnol. 2016, 233, 106–120. [Google Scholar] [CrossRef] [PubMed]
- Barboza, G.E.; Cantero, J.; Nuñez, C.; Ariza, L. Flora Medicinal de la Provincia de Córdoba (Argentina): Pteridófitas y Antófitas Silvestres o Naturalizadas; Museo Botánico Córdoba: Córdoba, Spain, 2006; ISBN 9879869419. [Google Scholar]
- Sandberg, F. 270 Plantas medicinales Ibero-americanas. J. Ethnopharmacol. 1996, 53, 55–56. [Google Scholar] [CrossRef]
- Lahitte, H.B.; Hurrel, J.A.; Belgrano, M.J.; Jankowiski, L.; Halona, P.; Mehltreter, K. Plantas Medicinales Rioplatenses; Ed. LOLA: Buenos Aires, Argentia, 1998; p. 240. [Google Scholar]
- Celaya, L.S.; Alabrudzińska, M.H.; Molina, A.C.; Viturro, C.I.; Moreno, S. The inhibition of methicillin-resistant Staphylococcus aureus by essential oils isolated from leaves and fruits of Schinus areira depending on their chemical compositions. Acta Biochim. Pol. 2014, 61, 41–46. [Google Scholar] [CrossRef] [PubMed]
- Cutro, A.C.; Castelli, M.V.; López, S.N.; Rosales, M.A.; Hollmann, A.; Rodriguez, S.A. Chemical composition of Schinus areira essential oil and antimicrobial action against Staphylococcus aureus. Nat. Prod. Res. 2021, 35, 2931–2936. [Google Scholar] [CrossRef] [PubMed]
- Turek, C.; Stintzing, F.C. Stability of essential oils: A review. Compr. Rev. Food Sci. Food Saf. 2013, 12, 40–53. [Google Scholar] [CrossRef]
- Majeed, H.; Bian, Y.-Y.; Ali, B.; Jamil, A.; Majeed, U.; Khan, Q.F.; Iqbal, K.J.; Shoemaker, C.F.; Fang, Z. Essential oil encapsulations: Uses, procedures, and trends. RSC Adv. 2015, 5, 58449–58463. [Google Scholar] [CrossRef]
- Heckler, C.; Marques Maders Silva, C.; Ayres Cacciatore, F.; Daroit, D.J.; da Silva Malheiros, P. Thymol and carvacrol in nanoliposomes: Characterization and a comparison with free counterparts against planktonic and glass-adhered Salmonella. Lwt 2020, 127, 109382. [Google Scholar] [CrossRef]
- Pérez-Conesa, D.; Cao, J.; Chen, L.; McLandsborough, L.; Weiss, J. Inactivation of Listeria monocytogenes and Escherichia coli O157:H7 biofilms by micelle-encapsulated eugenol and carvacrol. J. Food Prot. 2011, 74, 55–62. [Google Scholar] [CrossRef]
- Avila Gandra, E.; Radünz, M.; Helbig, E.; Dellinghausen Borges, C.; Kuka Valente Gandra, T. A Mini-Review on Encapsulation of Essential Oils. J. Anal. Pharm. Res. 2018, 7, 205. [Google Scholar] [CrossRef] [Green Version]
- Paul, S.; Hmar, E.B.L.; Zothantluanga, J.H.; Sharma, H.K. Essential oils: A review on their salient biological activities and major delivery strategies. Sci. Vis. 2020, 20, 54–71. [Google Scholar] [CrossRef]
- Pedro, A.S.; Santo, I.E.; Silva, C.V.; Detoni, C.; Albuquerque, E. The use of nanotechnology as an approach for essential oil-based formulations with antimicrobial activity. Curr. Res. Technol. Educ. Top. Appl. Microbiol. Microb. Biotechnol. 2013, 2, 1364–1374. [Google Scholar]
- Sherry, M.; Charcosset, C.; Fessi, H.; Greige-Gerges, H. Essential oils encapsulated in liposomes: A review. J. Liposome Res. 2013, 23, 268–275. [Google Scholar] [CrossRef]
- Hammoud, Z.; Gharib, R.; Fourmentin, S.; Elaissari, A.; Greige-Gerges, H. New findings on the incorporation of essential oil components into liposomes composed of lipoid S100 and cholesterol. Int. J. Pharm. 2019, 561, 161–170. [Google Scholar] [CrossRef]
- de Alteriis, E.; Maione, A.; Falanga, A.; Bellavita, R.; Galdiero, S.; Albarano, L.; Salvatore, M.M.; Galdiero, E.; Guida, M. Activity of Free and Liposome-Encapsulated Essential Oil from Lavandula angustifolia against Persister-Derived Biofilm of Candida auris. Antibiotics 2022, 11, 26. [Google Scholar] [CrossRef]
- Sun, Z.; Harris, H.M.B.; McCann, A.; Guo, C.; Argimón, S.; Zhang, W.; Yang, X.; Jeffery, I.B.; Cooney, J.C.; Kagawa, T.F.; et al. Expanding the biotechnology potential of lactobacilli through comparative genomics of 213 strains and associated genera. Nat. Commun. 2015, 6, 8322. [Google Scholar] [CrossRef] [Green Version]
- Prakash, B.; Kujur, A.; Yadav, A.; Kumar, A.; Singh, P.P.; Dubey, N.K. Nanoencapsulation: An efficient technology to boost the antimicrobial potential of plant essential oils in food system. Food Control 2018, 89, 1–11. [Google Scholar] [CrossRef]
- Vilas, V.; Philip, D.; Mathew, J. Catalytically and biologically active silver nanoparticles synthesized using essential oil. Spectrochim. Acta-Part A Mol. Biomol. Spectrosc. 2014, 132, 743–750. [Google Scholar] [CrossRef]
- Veisi, H.; Dadres, N.; Mohammadi, P.; Hemmati, S. Green synthesis of silver nanoparticles based on oil-water interface method with essential oil of orange peel and its application as nanocatalyst for A3 coupling. Mater. Sci. Eng. C 2019, 105, 110031. [Google Scholar] [CrossRef] [PubMed]
- Xu, L.; Wang, Y.-Y.; Huang, J.; Chen, C.-Y.; Wang, Z.-X.; Xie, H. Silver nanoparticles: Synthesis, medical applications and biosafety. Theranostics 2020, 10, 8996. [Google Scholar] [CrossRef]
- Shanmuganathan, R.; Karuppusamy, I.; Saravanan, M.; Muthukumar, H.; Ponnuchamy, K.; Ramkumar, V.S.; Pugazhendhi, A. Synthesis of Silver Nanoparticles and their Biomedical Applications-A Comprehensive Review. Curr. Pharm. Des. 2019, 25, 2650–2660. [Google Scholar] [CrossRef] [PubMed]
- Lee, S.H.; Jun, B.H. Silver nanoparticles: Synthesis and application for nanomedicine. Int. J. Mol. Sci. 2019, 20, 865. [Google Scholar] [CrossRef] [Green Version]
- Lekha, D.C.; Shanmugam, R.; Madhuri, K.; Dwarampudi, L.P.; Bhaskaran, M.; Kongara, D.; Tesfaye, J.L.; Nagaprasad, N.; Bhargavi, V.L.N.; Krishnaraj, R. Review on Silver Nanoparticle Synthesis Method, Antibacterial Activity, Drug Delivery Vehicles, and Toxicity Pathways: Recent Advances and Future Aspects. J. Nanomater. 2021, 2021, 4401829. [Google Scholar] [CrossRef]
- Abdoli, M.; Mohammadi, G.; Mansouri, K.; Khaledian, S.; Taran, M.; Martinez, F. A review on anticancer, antibacterial and photo catalytic activity of various nanoparticles synthesized by probiotics. J. Biotechnol. 2022, 354, 63–71. [Google Scholar] [CrossRef] [PubMed]
- Bigliani, M.C.; Rossetti, V.; Grondona, E.; Lo Presti, S.; Paglini, P.M.; Rivero, V.; Zunino, M.P.; Ponce, A.A. Chemical compositions and properties of Schinus areira L. essential oil on airway inflammation and cardiovascular system of mice and rabbits. Food Chem. Toxicol. 2012, 50, 2282–2288. [Google Scholar] [CrossRef]
- Abouaitah, K.; Lojkowski, W. Nanomedicine as an Emerging Technology to Foster Application of Essential Oils to Fight Cancer. Pharmaceuticals 2022, 15, 793. [Google Scholar] [CrossRef] [PubMed]
- Detoni, C.B.; Cabral-Albuquerque, E.C.M.; Hohlemweger, S.V.A.; Sampaio, C.; Barros, T.F.; Velozo, E.S. Essential oil from Zanthoxylum tingoassuiba loaded into multilamellar liposomes useful as antimicrobial agents. J. Microencapsul. 2009, 26, 684–691. [Google Scholar] [CrossRef] [PubMed]
- Ortan, A.; Câmpeanu, G.; Dinu-Pîrvu, C.; Popescu, L. Studies concerning the entrapment of Anethum graveolens essential oil in liposomes. Rom. Biotechnol. Lett. 2009, 14, 4411–4417. [Google Scholar]
- Garzoli, S.; Petralito, S.; Ovidi, E.; Turchetti, G.; Laghezza Masci, V.; Tiezzi, A.; Trilli, J.; Cesa, S.; Casadei, M.A.; Giacomello, P.; et al. Lavandula x intermedia essential oil and hydrolate: Evaluation of chemical composition and antibacterial activity before and after formulation in nanoemulsion. Ind. Crops Prod. 2020, 145, 112068. [Google Scholar] [CrossRef]
- Hammoud, Z.; Kayouka, M.; Trifan, A.; Sieniawska, E.; Ben Jemâa, J.M.; Elaissari, A.; Greige-Gerges, H. Encapsulation of α-pinene in delivery systems based on liposomes and cyclodextrins. Molecules 2021, 26, 6840. [Google Scholar] [CrossRef]
- Rodriguez, S.A.; Pinto, O.A.; Hollmann, A. Interaction of semiochemicals with model lipid membranes: A biophysical approach. Colloids Surf. B Biointerfaces 2018, 161, 413–419. [Google Scholar] [CrossRef]
- Smitha, S.L.; Nissamudeen, K.M.; Philip, D.; Gopchandran, K.G. Studies on surface plasmon resonance and photoluminescence of silver nanoparticles. Spectrochim. Acta-Part A Mol. Biomol. Spectrosc. 2008, 71, 186–190. [Google Scholar] [CrossRef]
- Zhao, L.; Temelli, F.; Curtis, J.M.; Chen, L. Preparation of liposomes using supercritical carbon dioxide technology: Effects of phospholipids and sterols. Food Res. Int. 2015, 77, 63–72. [Google Scholar] [CrossRef]
- Turina, A.D.V.; Nolan, M.V.; Zygadlo, J.A.; Perillo, M.A. Natural terpenes: Self-assembly and membrane partitioning. Biophys. Chem. 2006, 122, 101–113. [Google Scholar] [CrossRef]
- Porfírio, E.M.; Melo, H.M.; Pereira, A.M.G.; Cavalcante, T.T.A.; Gomes, G.A.; De Carvalho, M.G.; Costa, R.A.; Catunda, F.E.A. In vitro antibacterial and antibiofilm activity of lippia alba essential oil, citral, and carvone against Staphylococcus aureus. Sci. World J. 2017, 2017, 4962707. [Google Scholar] [CrossRef] [Green Version]
- Deveci, O.; Sukan, A.; Tuzun, N.; Kocabas, E.E.H. Chemical composition, repellent and antimicrobial activity of Schinus molle L. J. Med. Plants Res. 2010, 4, 2211–2216. [Google Scholar] [CrossRef]
- do Rosário Martins, M.; Arantes, S.; Candeias, F.; Tinoco, M.T.; Cruz-Morais, J. Antioxidant, antimicrobial and toxicological properties of Schinus molle L. essential oils. J. Ethnopharmacol. 2014, 151, 485–492. [Google Scholar] [CrossRef] [PubMed] [Green Version]
- Cimino, C.; Maurel, O.M.; Musumeci, T.; Bonaccorso, A.; Drago, F.; Souto, E.M.B.; Pignatello, R.; Carbone, C. Essential oils: Pharmaceutical applications and encapsulation strategies into lipid-based delivery systems. Pharmaceutics 2021, 13, 327. [Google Scholar] [CrossRef]
- Varona, S.; Rojo, S.R.; Martín, Á.; Cocero, M.J.; Serra, A.T.; Crespo, T.; Duarte, C.M.M. Antimicrobial activity of lavandin essential oil formulations against three pathogenic food-borne bacteria. Ind. Crops Prod. 2013, 42, 243–250. [Google Scholar] [CrossRef]
- Khezri, K.; Farahpour, M.R.; Mounesi Rad, S. Efficacy of Mentha pulegium essential oil encapsulated into nanostructured lipid carriers as an in vitro antibacterial and infected wound healing agent. Colloids Surf. A Physicochem. Eng. Asp. 2020, 589, 124414. [Google Scholar] [CrossRef]
- Allenspach, M.; Steuer, C. α-Pinene: A never-ending story. Phytochemistry 2021, 190, 112857. [Google Scholar] [CrossRef]
- Leite, A.M.; Lima, E.D.O.; De Souza, E.L.; Diniz, M.D.F.F.M.; Trajano, V.N.; De Medeiros, I.A. Inhibitory effect of β-pinene, α-pinene and eugenol on the growth of potential infectious endocarditis causing Gram-positive bacteria. Rev. Bras. Ciencias Farm. J. Pharm. Sci. 2007, 43, 121–126. [Google Scholar] [CrossRef] [Green Version]
- Wang, C.-Y.; Chen, Y.-W.; Hou, C.-Y. Antioxidant and antibacterial activity of seven predominant terpenoids. Int. J. food Prop. 2019, 22, 230–238. [Google Scholar] [CrossRef] [Green Version]
- da Silva Rivas, A.C.; Lopes, P.M.; de Azevedo Barros, M.M.; Costa Machado, D.C.; Alviano, C.S.; Alviano, D.S. Biological activities of α-pinene and β-pinene enantiomers. Molecules 2012, 17, 6305–6316. [Google Scholar]
- Bastús, N.G.; Merkoçi, F.; Piella, J.; Puntes, V. Synthesis of highly monodisperse citrate-stabilized silver nanoparticles of up to 200 nm: Kinetic control and catalytic properties. Chem. Mater. 2014, 26, 2836–2846. [Google Scholar] [CrossRef]
- Ameen, F.; Srinivasan, P.; Selvankumar, T.; Kamala-Kannan, S.; Al Nadhari, S.; Almansob, A.; Dawoud, T.; Govarthanan, M. Phytosynthesis of silver nanoparticles using Mangifera indica flower extract as bioreductant and their broad-spectrum antibacterial activity. Bioorg. Chem. 2019, 88, 102970. [Google Scholar] [CrossRef]
- Lara, H.H.; Ayala-Núñez, N.V.; del Turrent, L.C.I.; Padilla, C.R. Bactericidal effect of silver nanoparticles against multidrug-resistant bacteria. World J. Microbiol. Biotechnol. 2010, 26, 615–621. [Google Scholar] [CrossRef]
- Muniyappan, N.; Nagarajan, N.S. Green synthesis of gold nanoparticles using Curcuma pseudomontana essential oil, its biological activity and cytotoxicity against human ductal breast carcinoma cells T47D. J. Environ. Chem. Eng. 2014, 2, 2037–2044. [Google Scholar] [CrossRef]
- Vilas, V.; Philip, D.; Mathew, J. Biosynthesis of Au and Au/Ag alloy nanoparticles using Coleus aromaticus essential oil and evaluation of their catalytic, antibacterial and antiradical activities. J. Mol. Liq. 2016, 221, 179–189. [Google Scholar] [CrossRef]
- Rai, M.; Zacchino, S.; Derita, M. Essential Oils and Nanotechnology for Treatment of Microbial Diseases; Routledge: Abingdon, UK, 2017. [Google Scholar]
- Adams, R.; Sparkman, O. Review of Identification of Essential Oil Components by Gas Chromatography/Mass Spectrometry. J. Am. So.c Mass Spectrom 2007, 18, 803–806. [Google Scholar]
- Bangham, A.D.; Hill, M.W.; Miller, N.G.A. Preparation and Use of Liposomes as Models of Biological Membranes. In Methods in Membrane Biology; Springer: Boston, MA, USA, 1974; pp. 1–68. [Google Scholar]
- Varona, S.; Martín, Á.; Cocero, M.J. Liposomal incorporation of lavandin essential oil by a thin-film hydration method and by particles from gas-saturated solutions. Ind. Eng. Chem. Res. 2011, 50, 2088–2097. [Google Scholar] [CrossRef]
- Gorup, L.F.; Longo, E.; Leite, E.R.; Camargo, E.R. Moderating effect of ammonia on particle growth and stability of quasi-monodisperse silver nanoparticles synthesized by the Turkevich method. J. Colloid Interface Sci. 2011, 360, 355–358. [Google Scholar] [CrossRef] [Green Version]
- Provencher, S.W. CONTIN: A general purpose constrained regularization program for inverting noisy linear algebraic and integral equations. Comput. Phys. Commun. 1982, 27, 229–242. [Google Scholar] [CrossRef]
- National Committee for Clinical Laboratory Standards, N. M02-A12: Performance Standards for Antimicrobial Disk Susceptibility Tests; Approved Standard—Twelfth Edition. Clin. Lab. Stand. Inst. 2015, 35, 73. [Google Scholar]
- de Matos, S.P.; Lucca, L.G.; Koester, L.S. Essential oils in nanostructured systems: Challenges in preparation and analytical methods. Talanta 2019, 195, 204–214. [Google Scholar] [CrossRef]

| Compound 1 | RI 2 | Literature RI 3 | Area (%) 4 |
|---|---|---|---|
 α-pinene | 931 | 931 | 9.33 ± 0.07 |
 camphene | 950 | 951 | 0.98 ± 0.05 |
 β-pinene | 984 | 984 | 11.11 ± 0.16 |
 β-myrcene | 990 | 990 | 2.78 ± 0.03 |
 limonene | 1042 | 1040 | 0.66 ± 0.02 |
 β-phellandrene | 1045 | 1045 | 1.79 ± 0.03 |
 γ-terpinen | 1064 | 1064 | 0.15 ± 0.01 |
 1-terpinen-4-ol | 1170 | 1170 | 0.13 ± 0.01 |
 α-terpineol | 1198 | 1198 | 0.061 ± 0.003 |
 4-terpinenyl acetate | 1330 | 1335 | 1.54 ± 0.07 |
 α-cubebene | 1341 | 1341 | 0.10 ± 0.02 |
 β-cubebene | 1388 | 1388 | 0.55 ± 0.01 |
 β-elemene | 1393 | 1393 | 0.98 ± 0.02 |
 β-caryophyllene | 1437 | 1437 | 4.56 ± 0.13 |
 aromadendrene | 1460 | 1460 | 1.04 ± 0.03 |
 α-humulene | 1474 | 1474 | 1.11 ± 0.21 |
 alloaromadendrene | 1479 | 1479 | 6.13 ± 0.12 |
 cis-α-bisabolene | 1490 | 1493 | 4.08 ± 0.15 |
 (Z,Z)-α-farnesene | 1499 | 1499 | 5.45 ± 0.23 |
 δ-cadinene | 1533 | 1533 | 11.50 ± 0.98 |
 spathulenol | 1570 | 1570 | 2.46 ± 0.16 |
 viridiflorol | 1597 | 1597 | 0.79 ± 0.02 |
 nerolidol | 1623 | 1608 | 1.12 ± 0.02 |
 δ -cadinol | 1634 | 1634 | 0.90 ± 0.01 |
 β-eudesmol | 1642 | 1642 | 4.17 ± 0.13 |
 1-epi-cadinol | 1653 | 1645 | 22.67 ± 0.34 |
 α-cadinol | 1673 | 1673 | 0.62 ± 0.01 |
 α-bisabolol | 1684 | 1684 | 3.25 ± 0.17 |
| Formulation 1 | E. coli | S. aureus | ||
|---|---|---|---|---|
| MIC | MBC | MIC | MBC | |
| Pure EO 1 | - | - | 0.3 mg/mL | 0.3 mg/mL |
| DPPC/EO 1 | - | - | 3 mg/mL | - |
| DMPC/EO 1 | - | - | . | - |
| AgNPs with EO 2 | 6.68 µg/mL | 26.75 µg/mL | 3.4 µg/mL | 6.8 µg/mL |
| AgNPs with citrate 2 | 3.4 µg/mL | 26.75 µg/mL | 3.4 µg/mL | 26.75 µg/mL |
Disclaimer/Publisher’s Note: The statements, opinions and data contained in all publications are solely those of the individual author(s) and contributor(s) and not of MDPI and/or the editor(s). MDPI and/or the editor(s) disclaim responsibility for any injury to people or property resulting from any ideas, methods, instructions or products referred to in the content. |
© 2023 by the authors. Licensee MDPI, Basel, Switzerland. This article is an open access article distributed under the terms and conditions of the Creative Commons Attribution (CC BY) license (https://creativecommons.org/licenses/by/4.0/).
Share and Cite
Cutro, A.C.; Ferreyra Maillard, A.; Dalmasso, P.R.; Rodriguez, S.A.; Hollmann, A. Antimicrobial Nanoformulations Based on Schinus areira Essential Oil. Drugs Drug Candidates 2023, 2, 498-515. https://doi.org/10.3390/ddc2020026
Cutro AC, Ferreyra Maillard A, Dalmasso PR, Rodriguez SA, Hollmann A. Antimicrobial Nanoformulations Based on Schinus areira Essential Oil. Drugs and Drug Candidates. 2023; 2(2):498-515. https://doi.org/10.3390/ddc2020026
Chicago/Turabian StyleCutro, Andrea C., Anike Ferreyra Maillard, Pablo R. Dalmasso, Sergio A. Rodriguez, and Axel Hollmann. 2023. "Antimicrobial Nanoformulations Based on Schinus areira Essential Oil" Drugs and Drug Candidates 2, no. 2: 498-515. https://doi.org/10.3390/ddc2020026
APA StyleCutro, A. C., Ferreyra Maillard, A., Dalmasso, P. R., Rodriguez, S. A., & Hollmann, A. (2023). Antimicrobial Nanoformulations Based on Schinus areira Essential Oil. Drugs and Drug Candidates, 2(2), 498-515. https://doi.org/10.3390/ddc2020026








